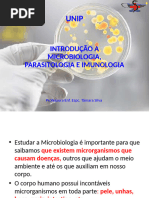

0% acharam este documento útil (0 voto)
61 visualizações15 páginasVírus e Bactérias: Estruturas e Funções
O documento descreve as principais características de vírus e bactérias. Vírus não são celulares e dependem de células hospedeiras para se reproduzirem, enquanto bactérias são células procarióticas capazes de se autorreproduzirem. O documento também explica como vírus e bactérias variam em tamanho, composição e forma.
Enviado por
Sara FerreiraDireitos autorais
© © All Rights Reserved
Levamos muito a sério os direitos de conteúdo. Se você suspeita que este conteúdo é seu, reivindique-o aqui.
Formatos disponíveis
Baixe no formato PDF, TXT ou leia on-line no Scribd
0% acharam este documento útil (0 voto)
61 visualizações15 páginasVírus e Bactérias: Estruturas e Funções
O documento descreve as principais características de vírus e bactérias. Vírus não são celulares e dependem de células hospedeiras para se reproduzirem, enquanto bactérias são células procarióticas capazes de se autorreproduzirem. O documento também explica como vírus e bactérias variam em tamanho, composição e forma.
Enviado por
Sara FerreiraDireitos autorais
© © All Rights Reserved
Levamos muito a sério os direitos de conteúdo. Se você suspeita que este conteúdo é seu, reivindique-o aqui.
Formatos disponíveis
Baixe no formato PDF, TXT ou leia on-line no Scribd